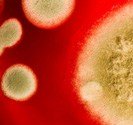
Pityriasis versicolor

Sommaire
- Résumé du psoriasis
- Synonymes du psoriasis
- Qu’est-ce que le psoriasis ?
- Qu’est-ce qui provoque le psoriasis ?
- Quels sont les sujets à risque ?
- Quels sont les symptômes du psoriasis ?
- Localisations particulières du psoriasis ?
- Psoriasis du corps
- Comment diagnostiquer le psoriasis ?
- Quelles affections peuvent être confondues avec le psoriasis ?
- Quelle est l’évolution du psoriasis ?
Résumé du psoriasis
Le psoriasis est une affection de la peau d’évolution chronique. Cette dermatose souvent familiale est à composante auto-immune. Elle affecte en général la peau, les ongles, le cuir chevelu, les muqueuses et/ou les articulations. On distingue cinq types de psoriasis cutané (psoriasis en plaques, en gouttes, des plis, érythrodermique et pustuleux) et 2 types de psoriasis articulaire (le rhumatisme psoriasique axial et périphérique). Le psoriasis en plaques, le plus fréquent des psoriasis, forme des taches ou plaques rouges, recouvertes de croûtes (pellicules de peau), blanches argentées (squames) qui se développent avec prédilection sur le cuir chevelu, les coudes, les genoux et le bas du dos. Les connaissances les plus récentes suggèrent que l’inflammation due au psoriasis aurait un rôle dans la survenue d’autres maladies qui y sont souvent associées – la dépression, le diabète, le surpoids, les troubles lipidiques (cholestérol et triglycérides) et les maladies cardiaques.
Synonymes du psoriasis
• Psoriasis en gouttes, psoriasis guttata • Psoriasis vulgaire, psoriasis en plaques, psoriasis annulaire, psoriasis crétacé, psoriasis hyperkératosique • Psoriasis des plis, psoriasis inversé • Psoriasis pustuleux généralisé, psoriasis pustuleux localisé, psoriasis pustuleux palmoplantaire • Psoriasis universalis, psoriasis érythrodermique • Psoriasis du cuir chevelu, sébopsoriasis • Psoriasis palmoplantaire, kératodermie palmoplantaire psoriasique • Psoriasis des organes génitaux, psoriasis génital, psoriasis du cuir chevelu, psoriasis des ongles, psoriasis unguéal, psoriasis buccal, langue géographique, psoriasis des muqueuses, psoriasis des langes • Psoriasis de l’enfant, psoriasis du nourrisson • Psoriasis arthropatique, rhumatisme psoriasique, psoriasis articulaire • Acrodermatite continue de Hallopeau, acrokératopériostite psoriasique
Qu’est-ce que le psoriasis ?
Le psoriasis est une maladie courante qui touche 2 à 5 % de la population française. Cette affection non contagieuse, survient sur un terrain génétique associé à des facteurs d’environnements (stress, infections, médicaments, etc…). En général bénigne, cette maladie est susceptible d’altérer parfois très sérieusement la qualité de vie des patients. Dans certains cas le psoriasis peut devenir une affection handicapante.
Le psoriasis est une maladie de la peau et/ou des articulations qui touche l’homme, la femme, l’enfant ou le nourrisson, il persiste le plus souvent toute la vie. Le psoriasis peut se déclencher à tout âge. L’atteinte de la peau, des articulations ou de toute autre localisation du corps peut se produire à un moment ou à un autre de l’évolution de la maladie. Le psoriasis évolue le plus souvent par « crises » ou poussées au cours desquelles l’affection peut s’aggraver ou s’améliorer. Ces poussées sont suivies par des périodes de rémissions où la dermatose (maladie de peau) s’améliore parfois même sans traitement. Il existe un certain nombre de cas où la maladie évolue de façon continue avec des fluctuations de la sévérité mais sans jamais complètement disparaitre.
Qu’est-ce qui provoque le psoriasis ?
Le psoriasis est une affection cutanée fréquente au cours de laquelle la couche superficielle de la peau se renouvelle trop rapidement. Le psoriasis est provoqué par une anomalie des cellules de la peau et une mauvaise interaction entre les couches superficielles (épiderme) et profondes (derme). Le psoriasis est entretenu par la réactivité des globules blancs. La cause de cette dermatose chronique n’est pas exactement connue, on constate une activité excessive des systèmes de défense de l’organisme. Le psoriasis comporte une réaction exagérée aux agressions de l’environnement.
Quels sont les sujets à risque ?
Le psoriasis est une affection familiale dans 30 à 50% des cas. Il est influencé par des facteurs liés à l’environnement qui peuvent le déclencher ou l’aggraver. C’est le cas du stress, des infections des voies aériennes supérieures, de la grippe ou des angines et pharyngites. Les traumatismes comme les démangeaisons, les blessures et coups répétés de la vie de tous les jours, les frottements (gant de crin, de toilette, tic d’arrachage, etc. ) peuvent déclencher une poussée de psoriasis à l’endroit même de ce traumatisme (phénomène de Kœbner). Le psoriasis est parfois aussi déclenché par la prise de certains médicaments, comme les bêtabloquants, les antipaludéens de synthèse, les inhibiteurs de l’enzyme de conversion, le lithium, certains anti-inflammatoires. La prise d’alcool est souvent corrélée à une aggravation du psoriasis ou au déclenchement d’une poussée. L’alcool est souvent une addiction chez les malades psoriasiques. L’exposition solaire améliore souvent le psoriasis (90 à 95%), mais peut rarement l’aggraver.
Quels sont les symptômes du psoriasis ?
L’atteinte de la peau, des articulations, des organes génitaux, du cuir chevelu ou des ongles peut se produire à n’importe quel moment de l’évolution de la maladie.
Psoriasis habituel dit vulgaire
Le psoriasis vulgaire se traduit par des plaques recouvertes de croûtes blanchâtres ou squames qui se développent sur des taches rouges (ou érythémateuses). L’atteinte des coudes, des genoux ainsi que les lésions du bas du dos sont fréquentes. Le psoriasis touche très souvent le cuir chevelu (95%) ou il forme des rougeurs sur lesquelles des pellicules plus ou moins épaisses se renouvellent en permanence. Ces croûtes démangent parfois de façon très intense.
Psoriasis en goutte ou psoriasis guttata
On rencontre souvent cette forme de début du psoriasis chez l’enfant ou elle fait parfois suite à une angine ou un rhume. Le psoriasis en gouttes ou guttata se caractérise par une éruption diffuse à toutes les parties du corps, composée de nombreux petits éléments arrondis rouges et squameux. Les démangeaisons sont fréquentes.
Psoriasis pustuleux
Cette variété de psoriasis forme des placards rouges avec des boutons purulents (pointes de pus) ou parfois uniquement des pustules éparpillées sur fond de peau normale. Le psoriasis pustuleux peut être localisé aux paumes et/ou aux plantes, aux ongles voire être généralisé à l’ensemble du corps. Le psoriasis pustleux généralisé s’accompagne alors de fièvre, d’une altération de l’état général (asthénie, anorexie, parfois amaigrissement, nausées) et souvent de douleurs articulaire.
Psoriasis des langes
Ce psoriasis du nourrisson touche la zone couverte par les langes, il se caractérise par des taches rouge-sombre à limites nettes plus ou moins squameuses.
Psoriasis de l’enfant
Le psoriasis de l’enfant débutent souvent après une angine et prend alors la forme d’un psoriasis dit « en gouttes » ou en plaques qui reste la forme la plus courante d’expression de cette maladie.
Localisations particulières du psoriasis ?
Psoriasis du corps
Psoriasis erythrodermique
Psoriasis généralisé à l’ensemble du corps. Il existe des rougeurs avec une desquamation le plus souvent fine touchant tout le corps de la tête aux pieds. Cette forme de psoriasis peut s’accompagner de signes généraux avec une fièvre, une hypothermie ou une déshydratation. Il s’agit d’un psoriasis grave requérant souvent une hospitalisation et une prise en charge spécifique en milieu spécialisé.
Psoriasis des mains et des pieds ou psoriasis palmo-plantaire
Cette forme de psoriasis localisé aux paumes et aux plantes se caractérise par des placards crouteux épais et/ou kératosiques bordés et sur fond rouge inflammatoire.
Psoriasis des plis ou psoriasis inversé
L’atteinte des plis se traduit par des rougeurs de l’aine, des aisselles, du pli inter fessier du nombril, de la région autour de l’anus et parois des espaces interdigitaux plantaires, palmaires, retro auriculaires. Les démangeaisons sont fréquentes mais la desquamation est rarement observée.
Psoriasis du visage ou sebopsoriasis
L’atteinte du visage est plutôt rare au cours du psoriasis (5 à 10% des patients ont une atteinte du visage à un moment ou un autre de leur vie), elle peut se traduire par des plaques rouges et squameuses qui ressemblent à la dermite séborrhéique. On retrouve des taches rouges qui prédominent autour du nez, dans la région des sourcils et du front et dans les régions pileuses de la barbe. Les narines peuvent être atteintes chez certains patients.
Psoriasis des organes génitaux
L’atteinte de la région génitale est fréquente au cours du psoriasis, elle peut se traduire par des plaques rouges et souvent peu squameuses. Les plaques sont parfois de forme annulaire (en anneaux) sur le fourreau (corps de la verge), le gland et les bourses. Les zones du pubis peuvent être atteintes, elles peuvent alors être recouvertes de taches rouges et squameuses.
Psoriasis de la muqueuse buccale
Le psoriasis de la langue forme des plaques rouges qui sont parfois associées à un dépôt blanchâtre facilement détachable. Ces plaques semodifient quotidiennement et forment la langue géographique. Parfois, le psoriasis lingual se traduit par une langue dépapillée.
Psoriasis des ongles
La majorité des patients qui ont un psoriasis auront une atteinte unguéale au cours de leur vie (75% selon une étude), Le psoriasis des ongles peut être la première manifestation de la maladie ou se manifester après plusieurs années d’évolution. Les patients qui ont un psoriasis des ongles présentent souvent une atteinte articulaire (environ 80%). L’atteinte des ongles est en général discrète, elle peut se manifester par de petits trous en dès à coudre, de petites taches jaune orangées, des taches blanches ou de petits traits noirs au bout de l’ongle. Lorsque l’atteinte est plus importante, on peut observer des zones blanches qui se décollent, un ongle dont la surface est rugueuse, une coloration jaune ou verte, un ongle très épais et jaunâtre ou un ongle ondulé ou tout cabossé. Un bourrelet rouge est parfois présent à la base de l’ongle, il peut faire croire à une infection (panaris). De faux panaris peuvent se produire au cours du psoriasis pustuleux qui provoque la survenue de petites « cloques » de pus sous l’ongle ou autour du doigt. On rencontre aussi plus rarement un gros orteil augmenté de volume avec un ongle jaune et épais. Au pire, l’ongle est remplacé par des croûtes épaisses. Le psoriasis des ongles altère temporairement sa croissance, celui-ci repousse ensuite normalement sauf en cas d’atteinte grave que l’on peut rencontrer au cours des psoriasis pustuleux (« cloques ou pustules » avec un liquide ou écoulement de pus). Ces signes précédemment décrits peuvent être diversement associés.
Le psoriasis des ongles est souvent confondu avec une mycose (un champignon), c’est la raison pour laquelle un prélèvement mycologique est souvent nécessaire pour s’assurer de l’absence de champignon, particulièrement sur les pieds. En fait on peut avoir une infection mycosique, une atteinte psoriasique ou les 2, car cette dernière favorise la première. Certaines formes de psoriasis des ongles sont trompeuses et peuvent être confondues avec un panaris infectieux. Quand l’ongle est décollé, il peut prendre une coloration verte liée à l’infection concomitante par des bactéries.
Le diagnostic de psoriasis des ongles est difficile, il nécessite le recours à un spécialiste qui peut décider de l’opportunité d’un prélèvement à la recherche de champignons, de bactéries ou de virus. Une biopsie de l’ongle affecté est parfois nécessaire, surtout quand l’aspect est inhabituel et que l’atteinte porte sur un seul ongle.
Le traitement du psoriasis des ongles est très difficile car les crèmes ne pénètrent pas à travers l’ongle. La protection des traumatismes est nécessaire pour éviter le phénomène d’aggravation qui survient lors des chocs liés par exemple à l’activité professionnelle ou sportive, il faut aussi éviter les contacts excessifs avec l’humidité et les manucures (nettoyage sous l’ongle). Les atteintes les plus discrètes (petits trous, ongle rugueux, taches jaunes) sont pris en charge par des soins cosmétiques (limage et polissage de la surface de l’ongle, laques colorées chez les femmes).
Psoriasis du cuir chevelu, psoriasis des cheveux
L’atteinte du cuir chevelu est extrêmement fréquente au cours du psoriasis, c’est même souvent la localisation initiale ou première de la maladie. Certains psoriasis sont localisés uniquement au cuir chevelu pendant toute la vie. Au début, le psoriasis du cuir chevelu n’est pas très caractéristique, il peut se manifester par de petites plaques roses qui pèlent et ressemblent fort à un état pelliculaire plus ou moins sévère. Le psoriasis du cuir chevelu se manifeste en général par des taches rouges qui se recouvrent progressivement de croûtes argentées de plus en plus épaisses. Au maximum le crâne se recouvre de croûtes épaisses qui débordent à la lisière du cuir chevelu, les démangeaisons sont souvent importantes. Plus souvent, les plaques rouges et croûteuses sont localisées à l’arrière du crâne ou seulement sur les tempes, prenant parfois tout le crâne (casque du cuir chevelu).
Le psoriasis du cuir chevelu peut être associé à des atteintes corporelles ou unguéales mais aussi à l’atteinte du visage qui devient rouge et pèle, plus particulièrement au front et autour du nez. L’atteinte des conduits auditifs externes s’associe souvent à la localisation du cuir chevelu. Le psoriasis des conduits auditifs forme des squames croûtes pouvant au maximum constituer un bouchon. Les squames du conduit auditif entraînent des démangeaisons intenses, l’utilisation intempestives de coton tige est d’ailleurs responsable de nombreux accidents de perforation du tympan. L’utlisation des cotons tiges entretien la survenue des plaques des conduits auditifs durant des années. Les plaques les plus typiques d’une atteinte psoriasique du cuir chevelu sont celles des régions retro auriculaires, de l’occiput et de la lisière du cuir chevelu sur le front. Le psoriasis du cuir chevelu n’entraîne pas de chute de cheveux permanente. On peut parfois observer une chute temporaire (effluvium télogène) lors des poussées importantes (dites très inflammatoires) ou au décours du traitement d’un psoriasis crouteux du cuir chevelu.
Au début, l’affection est parfois confondue avec un simple état pelliculaire ou une dermite séborrhéique surtout chez les patients qui n’ont pas d’autres atteintes sur le reste du corps.
Le dermatologue fait aisément le diagnostic de psoriasis du cuir chevelu et aucun examen complémentaire n’est le plus souvent requis. Dans certains cas, un prélèvement mycologique ou même une biopsie peuvent être demandés.
Psoriasis des articulations ou arthropathique
Atteinte articulaire liée au psoriasis. C’est une forme de psoriasis associant une atteinte cutané et une atteinte articulaire, celle ci peut rester discrète ou être destructrice comme dans la polyarthrite rhumatoïde. en cas de psoriasis arthropathique, les marqueurs sanguins de la polyarthrite rhumatoïde sont absents. Deux types d’atteintes sont à distinguer, l’atteinte périphérique et l’atteinte axiale. Le rhumatisme périphérique psoriasique peut affecter les petites et/ou grosses articulations comme les les articulations des coudes, des genoux, des chevilles et les petites articulations de l’extrémité des doigts.
Le rhumatisme axial touche en général les articulations du cou ou le bas de la colonne vertebrale, parfois les articulations de la clavicule ou des côtes. Lorsque l’atteinte des articulations s’associe à une atteinte de la peau, on parle de psoriasis sévère. L’atteinte articulaire peut précéder l’atteinte de la peau dans 10 à 15% des cas. Mais dans les 75 à 80% des cas, c’est la peau qui est affectée en premier.
Les douleurs articulaires sont parfois être les seuls symptômes du psoriasis articulaire. Le diagnostic du psoriasis articulaire est fait en général par le dermatologue et/ou le rhumatologue.
Un certain nombre d’examens sont nécessaires, un bilan sanguin qui recherche des signes de l’inflammation et l’absence des marqueurs de la polyarthrite rhumatoide. Un bilan radiologique des articulations douloureuses est réalisé, une échographie voire une IRM sont parfois nécessaires.
Comment diagnostiquer le psoriasis ?
Dans sa forme commune (la plus fréquente), le diagnostic de psoriasis ne pose généralement pas de problème au dermatologue, il est basé sur le seul examen de la peau et des phanères. La présence de lésions en plaques rouges et squameuses sur les zones dites « bastion » (cuir chevelu, coudes, genoux, bas du dos) et/ou la présence de plaques du corps qui peuvent s’associer à une atteinte des ongles, des plis, des organes génitaux ou des articulations est en général suffisant. L’interrogatoire retrouve souvent des antécédents de psoriasis dans la famille du patient (chez les parents, les frères ou sœurs, les oncles, cousins, grands-parents du coté paternel ou maternel), mais ce n’est pas obligatoire.
Le diagnostic peut être délicat quand l’atteinte est minime ou seulement localisée à un ongle ou au cuir chevelu. Le dermatologue prescrit parfois des examens pour conforter son diagnostic (biopsie de peau) ou éliminer d’autres affections qui peuvent ressembler au psoriasis (prélèvement bactériologique ou viral, prise de sang, radiographies).
Quelles affections peuvent être confondues avec le psoriasis ?
De nombreuses affections cutanées peuvent être confondues avec un psoriasis : mycose, dermite séborrhéique, eczéma, allergie médicamenteuse, infection bactérienne ou virale.
|
Médicaments pouvant provoquer le plus fréquemment une éruption proche du psoriasis
|
| Antihypertenseurs | Bêta bloquants Inhibiteurs de l’enzyme de conversion Inhibiteurs calciques |
| Antipaludéens de synthèse | Nivaquine, hydroxychloroquine |
| Médicaments correcteur de l’humeur | Lithium |
| Anti inflammatoires non stéroidiens |
Quelle est l’évolution du psoriasis ?
Le psoriasis évolue le plus souvent par « crises » ou poussée au cours desquelles l’affection s’aggrave. Les poussées de la maladie sont en général suivies par des périodes de rémissions où le psoriasis s’améliore parfois même sans traitement. Cependant, il est fréquent que des stigmates de la maladie persistent à certains endroits, ces zones « bastion » comme les coudes, les jambes, le cuir chevelu ou les genoux sont souvent les plus résistantes aux traitements. Il n’est pas possible de prédire à l’avance l’évolution de la maladie qui est souvent rythmée par les « stress » mais aussi par une évolution propre.
Certains psoriasis sont très discrets, d’autres modérés et enfin encore d’autres dits sévères. A chaque patient correspond un mode d’évolution particulier ou s’imbriquent des facteurs liés à l’individu (génétique, type de peau, ethnie, nature psychologique) et d’autres liés à l’environnement (stress, profession, susceptibilité aux infections, prise de certains médicaments, activités quotidiennes. Les facteurs psychologiques jouent un rôle souvent important dans le déclenchement et/ou l’entretien de la maladie et/ou des poussées.
Classification du psoriasis
Psoriasis léger : psoriasis ne dépassant pas plus de 3 % de la surface cutanée totale atteinte (SCTA) et n’ayant pas d’impact (n’altérant pas) sur la qualité de vie du patient. Ce type de psoriasis requiers en général à un traitement local simple dont le risque d’effets secondaires est minime.
Psoriasis modéré : psoriasis touchant entre 3 et 10% de la surface cutanée totale atteinte avec un certain impact sur la qualité de vie du patient. Ce type de psoriasis requiers en général un traitement local et général dont le risque d’effets secondaires est modéré.
Psoriasis sévère : psoriasis touchant plus de 10% de la surface cutanée totale atteinte et ayant un impact important sur la qualité de vie du patient. Ces psoriaisis requiers un traitement général et local dont le risque d’effets secondaires peut être considéré comme important.
Psoriasis Grave : psoriasis érythrodermique, pustuleux généralisé, pustuleux localisé ou palmoplantaire, kératodermie palmoplantaire, rhumatisme psoriasique, psoriasis arthropatique, tout psoriasis devenant invalidant ou handicapant.
Quel sont les traitements du psoriasis ?
Il existe de nombreux traitements efficaces pour le psoriasis. Il est important de limiter ou d’éliminer les facteurs qui peuvent déclencher ou aggraver le psoriasis (médicaments, alcool, traumatismes, stress, etc.). Une fois la poussée maitrisée par un traitement initial adapté (traitement d’attaque), il est essentiel et capital de suivre un traitement d’entretien qui va permettre d’éviter ou prévenir la récidive.
Le traitement dépend de l’étendue, de la localisation, de l’expérience et de la préférence des patients mais aussi des contre indications liées aux pathologies associées, à l’âge ou au statut du patient (grossesse).
Traitements locaux du psoriasis
Traitements locaux du psoriasis léger à modéré : les traitements locaux font appels à des crèmes, pommades, gels ou lotions à base de :
1 – Cortisone : tableau des dermocroticoides
2 – Dérivés de la vitamine D (Daivonex®, Silkis®, Apsor®).
3 – Corticoide + acide salicylique : Diprosalic, Nerisalic, Betnesalic,
4 – Cortisone associée à la vitamine D : Daivobet®,
5 – Dioxyanthranol : short contact thérapie ou thérapie de contact de courte durée ou à durée déterminée.
Préparations magistrales à base de cortisone, acide salicylique, d’émollients, hydratants, antiprurigineux (anti démangeaisons).
Traitements internes du psoriasis
Traitements par voie générale du psoriasis modéré : le traitement par voie générale du psoriasis modéré à sévère fait appel aux dérivés de la vitamine A [rétinoïdes (Soriatane ®)] ou aux ultraviolets (ultraviolets A associés à la prise d’un photosensibilisant ou ultraviolets B TL01) parfois les 2 associés.
Photothérapies, lasers et lampes
Photothérapies UVA et UVB
La Puvathérapie et les UVB à spectre étroit (UVB TL01 à 311 nm) sont les deux modalités de photothérapie généralement utilisées pour traiter les formes étendues (la moitié de la surface du corps environ) et sévères de psoriasis en plaques ou en gouttes. Ce traitement est pris en charge par l’assurance maladie. Il existe des formes de PUVAthérapies localisées pour les psoriasis des paumes et des plantes et ceux du cuir chevelu. Les UVB à spectre étroit (308nm) peuvent aussi être utilisés pour un traitement très localisé grâce au laser et aux lampes excimère à 308 nm. Il existe enfin des appareils de maison qui peuvent délivrer des photothérapies ciblées à 311 nm.
L’exposition de la peau aux ultraviolets régule la prolifération des cellules de la peau et la réactivité des cellules de défense de l’organisme – elle a un effet bénéfique sur certaines formes de psoriasis. Certains psoriasis ne sont pas améliorés par les rayons ultraviolets.
Les photothérapies sont contre indiquées chez les enfants de moins de huit ans, les patients ayant un risque accru de cancer de la peau (antécédents de mélanome, traitements immunosuppresseurs) ou une réactivité anormale aux ultraviolets (lupus érythémateux, porphyrie).
La Puvathérapie est plus complexe à mettre en œuvre que les UVB, car il faut prendre un médicament photosensibilisant (mélanidine) avant de s’exposer aux rayons ultraviolets – il faut aussi porter des lunettes de protection dans les heures qui suivent. La PUVAthérapie reste cependant le traitement de référence et on peut obtenir une disparition quasi complète des lésions après 15 à 25 séances. Cette technique est préférable en cas de psoriasis plus sévères et chez les patients à peau foncée.
Il est plus difficile de trouver des praticiens avec des cabines UVB à spectre étroit qui ne nécessitent pas la prise de médicament – le risque cancérigène des UVB à spectre étroit serait inférieur à celui des UVA mais ce n’est pas prouvé. Cette technique est préférable dans les psoriasis modérés, chez l’enfant, l’insuffisant rénal ou la femme enceinte.
Les lampes et lasers excimère sont peu répandus, on en trouve à Paris, Nice et Lille. Ils sont utilisés pour traiter des plaques très localisées.
Les photothérapies ciblées peuvent être utilisées à la maison pour des plaques localisées, grâce à des appareils de photothérapies assez bon marché (200 € environ) vendus sur internet. Certains de ces appareils sont équipés de lampe Philips TL01 à 311 nm et d’un minuteur, ils permettent une photothérapie UVB ciblée sur de petites plaques du corps ou du cuir chevelu. Pour éviter des incidents et les traitements inadaptés, ces appareils doivent être utilisés après une formation et les conseils adaptés de votre dermatologue.
Les séances d’ultraviolet corps entier se font chez le dermatologue, trois fois par semaine jusqu’à rémission complète, un traitement d’entretien est parfois recommandé.
Les photothérapies favorisent les cancers de la peau et le risque de cataracte. C’est la raison pour laquelle il faut porter des lunettes dans les douze heures qui suivent la prise de psoralène pour la PUVA, éviter d’exposer le visage et les organes génitaux, faire contrôler sa peau régulièrement chez le dermatologue et ne pas dépasser le nombre total de 250 séances (UVA et UVB compris).
Les photothérapies peuvent être associées à d’autres traitements pour de meilleurs résultats. Il est recommandé de décaper les plaques avant la photothérapie (retirer les croutes épaisses) grâce à un traitement local. Les traitements locaux du type dermocorticoides (crèmes à la cortisone), tazarotène (Zorac®) ou les dérivés de la vitamine A par voie orale (acitrétine) ont un effet synergique (augmentent l’efficacité) de la photothérapie.
Lasers excimère à 308 nm- le laser et les lampes excimère sont des traitements ultraviolets spécifiques (308nm) dont l’intérêt est démontré pour la prise en charge de plaques localisées de psoriasis.
Laser à colorant pulsé – les séances de laser à colorant peuvent aider au traitement de localisations particulières du psoriasis.
Dérivés de la Vitamine A
Acitrétine (Soriatane®)
L’acitrétine (Soriatane®) est un médicament de la classe des rétinoïdes qui sont molécules dérivées de la vitamine A.
L’acitrétine est prescrite isolément dans certaines formes de psoriasis (psoriasis pustuleux, psoriasis épais des paumes et des plantes, psoriasis des ongles). Dans les formes classiques de psoriasis, l’acitrétine est plus souvent recommandée en association avec des photothérapies (PUVAthérapie, ultraviolets B) ou des traitements locaux (calcipotriol, dermocorticoïdes) ou généraux.
Le problème posé par l’acitrétine est sa tératogénicité (risque de malformations de l’enfant en cas de prise pendant la grossesse), c’est la raison pour laquelle la contraception est obligatoire chez la femme pendant le traitement et deux ans après (du fait de la lenteur d’élimination du produit). La prise d’acitrétine provoque une sécheresse de la peau et des muqueuses (lèvres, conjonctives, nez) qui est facilement corrigée par des crèmes adaptées et une chute de cheveux. Une surveillance par prise de sang est nécessaire, car il existe souvent une élévation des graisses dans le sang (triglycérides, cholestérol) et parfois des enzymes du foie. Les inflammations sévères du foie sont rares. Les maux de tête peuvent témoigner d’un œdème du cerveau et nécessitent l’arrêt du traitement.
L’acitrétine est traitement efficace du psoriasis modéré chez l’homme jeune, il peut être associé aux traitements locaux ou à une photothérapie. Ce traitement est aussi intéressant pour les psoriasis pustuleux ou unguéaux.
Traitements du psoriasis modéré à sévère
Le méthotrexate (Novatrex®, Ledertrexate®, Metoject®, Méthotrexate Bellon®), ce traitement agit en freinant le renouvellement des cellules des couches superficielles de la peau. Ce traitement est utilisé depuis plus de 40 ans dans le traitement des cancers, on parle de chimiothérapie. Dans le psoriasis il est utilisé pour ses propriétés anti-inflammatoires plus qu’antiprolifératives et est administré à des doses 10 fois moins fortes dans le psoriasis que dans les cancers. Ses effets secondaires potentiels sont très bien connus et bien surveillés, ils ne présentent quasiment pas de danger pour le patient qui le prend. Une surveillance clinique et biologique (prises de sang régulières) est néanmoins nécessaire afin de dépister tout effet secondaire qui pourrait disparaitre avec la diminution de la dose ou en arrêtant le traitement. Une vitamine à base d’acide folique est par ailleurs souvent associée au traitement par méthotrexate, il s’agit d’un antidote du méthotrexate, qui va le neutraliser et qui est prise uniquement les jours où on ne prend pas le méthotrexate (en général 1 prise suffit dans les 48 heures suivant la prise de méthotrexate. Le but étant de minimiser les effets secondaires potentiels du méthotrexate et d’augmenter sa tolérance à court, moyen et long terme. Il faut éviter autant que possible de la prendre la veille du méthotrexate, sauf avis contraire de votre médecin.
La ciclosporine A (Néoral®, Sandimmun) est un médicament qui agit sur les lymphocytes T et empêche ces cellules de l’immunité de produire leurs substances inflammatoires, inhibant par la même l’inflammation de la peau et des articulations. Ce médicament est très efficace mais un peu toxique pour le rein et peut augmenter la tension artérielle, modifier les lipides dans le sang et parfois donner une hyperpilosité du visage, des problèmes de gencive et possède de multiples interactions médicamenteuses. Un contrôle sanguin du rein et de la tension est donc indispensable et impose de n’utiliser ce traitement que sur de courtes périodes allant de 4 à 6 mois voire 1 à 2 ans au grand maximum.
D’autres immunosuppresseurs sont possiblement indiqué quand tous les traitements précédents et les biologiques se sont avérés inefficaces ou non tolérés Il s’agit du Tacrolimus (Prograf), du Mycophenolate Mofetil (Cellecept), de l’Azathioprine (Imurel) et bien d’autres. Ces médicaments exigent une bonne connaissance du mode de leur utilisation, des effets secondaires potentielset de leur prise en charge (en général prescrits par des médecins qui ont l’habitude de les manier).
Biologiques
Les traitements biologiques agissent en inhibant la sécrétion de certaines substances inflammatoires responsables de la plaque psoriasique, ils dépriment en général le système de défense de l’organisme et peuvent favoriser des infections graves ou des cancers. Les traitements biologiques sont pris en charge par l’assurance maladie sous certaines conditions, leur coût est particulièrement élevé avec des prix de l’ordre de 1200 à 3000 € le mois de traitement.
Les biologiques font désormais partie d’une nouvelle famille de médicaments dans la prise en charge du psoriasis : c’est ce qu’on appelle les bio médicaments. Il s’agit d’un réel un vrai progrès dans la prise en charge de la maladie psoriasique, autrement dit le psoriasis et le rhumatisme psoriasique, mais aussi d’autres localisations difficiles à traiter comme l’atteinte unguéale, l’atteinte du cuir chevelu, celle du visage, etc.
Les biothérapies occupent actuellement dans la stratégie thérapeutique du psoriasis une place de 3ème ligne, après les topiques et les traitements systémiques. Cette place est en réalité en 4ème voire 5ème position, puisque l’AMM de tous les biologiques actuellement disponibles sur le marché européen est : psoriasis modéré à sévère avec échec, intolérance ou contre-indication à au moins deux traitements systémiques classiques parmi la photothérapie, le Methotrexate ou la Ciclosporine.
On pourrait expliquer cela au jour de l’obtention de ces AMM par :
1. le manque de recul en termes de tolérance et d’innocuité,
2. l’absence d’étude comparant ces molécules aux traitements systémiques,
3. l’absence d’essais comparant ces biothérapies entre elles
4. et enfin le prix élevé de ces molécules,
4 molécules sont présentes sur le marché actuellement : 3 molécules sont des anti TNF-a, parmi lesquelles on distingue un récepteur recombinant soluble d’origine humaine du TNF (a et ß) ; l’Etanercept (Enbrel®) et deux anticorps anti-TNF , l’un chimérique l’Infliximab ( Rémicade®) et le second totalement humain l’Adalimumab (Humira®) et une nouvelle molécule , une anti-cytokine l’Ustékinumab (Stelara®) , un anticorps humain anti-IL12/IL23 pour lequel la mise sur le marché français devrait se faire début 2010, et ce dès l’obtention du prix et qui est déjà utilisé actuellement en milieu hospitalier sur dérogation du ministère de la santé. D’autres molécules en voie de développement sont en cours comme le Briakinumab, le Golimumab, le Certolizumab, les anti IL-17 a et r, etc.
Etanercept – Enbrel®
Outre son efficacité prouvée dans le psoriasis et le rhumatisme psoriasique de l’adulte (A).
Il est le premier anti-TNF-a indiqué dans le psoriasis en plaques sévère chronique de l’enfant à partir de 8 ans et de l’adolescent, en cas de réponse inadéquate ou d’intolérance aux autres traitements systémiques ou à la photothérapie.
Ce médicament possède d’autres indications non dermatologiques, notamment chez l’adulte dans la polyarthrite rhumatoïde et la spondylarthrite ankylosante et, chez l’enfant, dans l’arthrite juvénile idiopathique.
Contre-indications et bilan préthérapeutique
Les contre-indications de l’étanercept comprennent l’hypersensibilité à l’étanercept ou à un excipient (mannitol, saccharose, trométamol), l’immunodéficience, les infections évolutives et les antécédents de cancer. Les vaccinations, la grossesse et l’allaitement sont évités sous étanercept. Une contraception appropriée est recommandée avant, pendant et au moins 6 mois après l’arrêt de l’étanercept.
Le bilan préthérapeutique comprend : examen clinique complet, intradermoréaction tuberculinique.
Le traitement par etanercept doit être débuté et surveillé par un médecin spécialiste des maladies inflammatoires chroniques dans lesquelles il est indiqué (en pratique, essentiellement : internistes, rhumatologues et dermatologues). Sa prescription initiale doit être hospitalière.
La dose recommandée dans le psoriasis en plaques est de 25 mg, 2x/semaine. Si l’état clinique du patient le nécessite, une dose de 50 mg, 2x/semaine, peut être administrée de la semaine 0 à la semaine 12. Les sites d’injection doivent être alternés. La posologie ne nécessite pas d’ajustement chez les patients de plus de 65 ans ou ayant une insuffisance hépatique ou rénale.
En l’absence de réponse clinique à la semaine 12, le traitement par etanercept ne doit pas être poursuivi. Le traitement ne doit pas être poursuivi au-delà de 24 semaines en l’absence de réévaluation de sa tolérance et de son efficacité.
En France, le coût de l’Enbrel était de 126 € pour 1 flacon de 25 mg et 252 € pour un flacon de 50 mg, en janvier 2009.
Infliximab – Remicade®
Remicade est indiqué dans : le traitement du psoriasis en plaques modéré à sévère de l’adulte en cas d’échec, ou de contre-indication, ou d’intolérance aux autres traitements systémiques y compris la ciclosporine, le méthotrexate ou la puvathérapie. 5 mg/kg administrés en perfusion intraveineuse d’une durée de 2 heures, suivis par des perfusions supplémentaires de 5 mg/kg aux semaines 2 et 6 après la première perfusion, puis ensuite toutes les 8 semaines.
Adalimumab -Humira®
HUMIRA est indiqué dans le traitement du psoriasis en plaques, modéré à sévère, chez les patients adultes qui ne répondent pas à d’autres traitements systémiques comme la ciclosporine, le méthotrexate ou la PUVA thérapie, ou chez lesquels ces traitements sont contre-indiqués ou mal tolérés. »
La posologie recommandée dans le rhumatisme psoriasique est une dose unique de 40 mg d’Adalimumab toutes les deux semaines, en injection par voie sous-cutanée.
La posologie recommandée chez l’adulte dans le psoriasis est de 80 mg par voie sous-cutanée le 1er jour, puis 40 mg la 1ère semaine puis 40 mg 1semaine sur 2.
Ustekinumab – Stelara®
Indiqué uniquement dans le psoriasis en plaques modéré à sévère de l’adulte en cas d’échec, ou de contre-indication, ou d’intolérance aux autres traitements systémiques y compris la ciclosporine, le méthotrexate ou la puvathérapiepour l’instant.
L’efficacité de l’Ustekinumab a été démontrée dans deux études versus placebo (PHOENIX 1 et 2) et dans une étude contre étanercept (ACCEPT). Il s’administre à la dose de 45 mg chez les patienst de moins de 100 kg et de 90 mg chez les patients de plus de 100 kg.
Recommandations pour la mise en route d’un des quatre traitements biologiques (infliximab, etanercept, adalimumab, ustekinumab).
Psoriasis sévère (c’est-à-dire un psoriasis dont le Psoriasis Area Severity Index (PASI) = 10 et Dermatology Life Quality Index (DLQI) = 10) et une forme de la maladie pour laquelle la photothérapie ou les autres traitements systémiques ne sont pas bien tolérés, contre-indiqués ou ne donnent pas des résultats satisfaisants (un résultat satisfaisant est défini par une réduction d’au moins 50% du PASI initial associé à une réduction de 5 points du DLQI ou bien une réduction d’au moins 75% du PASI initial).
L’adalimumab or etanercept sont les traitements biologiques don’t l’utilisation est recommandée en première intention alors que l’ustekinumab est réservé au traitement de seconde intention. L’nfliximab est recommandé lorsqu’un contrôle rapide de la maladie est nécessaire.
Traitement des formes particulières du psoriasis
Traitement du psoriasis des ongles et des cheveux
Le traitement du psoriasis des ongles ou des cheveux nécessite des stratégies particulières.
Traitement du psoriasis des cheveux :
Le traitement du psoriasis du cuir chevelu est très efficace mais contraignant, il nécessite des soins réguliers, soigneux et très consciencieux pour en venir à bout.
Traitements locaux : Ils font appel aux shampooings aux lotions et plus rarement aux crèmes ou pommades.
Les shampooings sont indispensable au traitement du psoriasis capillaire, ils permettent d’enlever les croûtes décollées par les traitements mais aussi d ‘éviter la récidive du psoriasis qui a été « blanchi ». Les shampooings réducteurs doivent être utilisés quotidiennement, ils sont à base de substances décapantes (réducteurs) comme les goudrons de bois (huile de cade ou de cèdre), l’acide salicylique ou la résorcine souvent associés dans la composition (Alphacade®, Squaphane S®, Nodé K®, Tgel fort). L’apparition récente d’un shampooing corticoïde (Clobex®) permet le traitement ou l’entretien du psoriasis capillaire modéré.
Psoriasis capillaire sévère : il nécessite un traitement d’attaque avec des pommades ou des crèmes qui associent une cortisone superpuissante (clobétasol, diproprionate de bétaméthasone) et un décapant (l’acide salicylique). L’application des préparations est très contraignante, elle se fait le soir raie par raie, la mise en place d’un bonnet de bain ou d’une charlotte est utile les premiers jours car elle renforce beaucoup l’efficacité de cette thérapeutique. Il est souvent nécessaire de réaliser plusieurs shampooings le matin pour se débarrasser des croûtes et de l’aspect très gras provoqué par ces préparations, les shampooings doivent toujours être laissés cinq à dix minutes sur le cuir chevelu avant rinçage. Dès que les croûte épaisses sont parties, il faut espacer les applications de préparations et associer des dérivés de la vitamine D ( Daivonex lotion®, Apsor solution®) éventuellement associés à des lotions à la cortisone (xamiol®, Dermoval gel®).
Psoriasis capillaire modéré : il est traité avec des lotions ou des shampooings corticoïdes (Clobex®, Dermoval gel®) ou des lotions à base de vitamine D (Daivonex lotion®, Apsor solution®) parfois associée à un corticoïde (Xamiol®). Il faut toujours diminuer très progressivement la fréquence des applications et conserver un traitement d’entretien dont la puissance et le rythme est fonction de l’intensité du psoriasis. L’utilisation de shampooings quotidiens est absolument indispensable pour éviter une récidive rapide, il faut laisser ces shampooings agir suffisamment longtemps pour être efficaces.
Les traitements internes du psoriasis du cuir chevelu sont identiques à ceux du psoriasis de la peau. Les traitements par voie générale sont utilisés quand l’atteinte du cuir chevelu est associée à une atteinte corporelle importante si les traitements usuels ne font pas effet. Il est exceptionnel d’avoir recours aux traitements internes pour un psoriasis isolé du cuir chevelu. La photothérapie n’est pas utilisée car les cheveux bloquent l’action de la lumière.
Les traitements du psoriasis capillaire sont très efficaces, ils permettent d’éliminer les symptômes pendant un temps mais n’évitent pas la récidive de la maladie, c’est la raison pour laquelle un traitement d’entretien est souvent indispensable.
Traitement du psoriasis des ongles
Le traitement du psoriasis difficile car les crèmes ne pénètrent pas à travers l’ongle. La protection des traumatismes est indispensable pour éviter le phénomène d’aggravation qui survient lors des chocs liés à l’activité professionnelle ou sportive, il faut aussi éviter les contacts excessifs avec l’humidité et les manucures (nettoyage sous l’ongle). Les atteintes les plus discrètes (petits trous, ongle rugueux, taches jaunes) sont pris en charge par des soins cosmétiques (limage et polissage de la surface de l’ongle, laques colorées chez les femmes).
Les traitements locaux font appel à des topiques ou aux injections locales. Les traitements topiques utilisent les pommades à base de cortisone les plus puissantes (Dermoval®, Diprolène®) et/ou les dérivés de la vitamine D (Daivobet®, Daivonex pommade®). En cas d’atteinte de la matrice de l’ongle (altération de la surface de l’ongle), les pommades doivent être appliquées à la racine de l’ongle. Lorsque l’atteinte touche le lit unguéal (ongle blanc et décollé) les pommades sont appliquées au niveau de la peau située sous l’ongle après le découpage de l’ongle qui est décollé. Le dermatologue recommande parfois de recouvrir la pomamde par un film plastique (occlusion) pour renforcer l’efficacité de cette thérapeutique. Les traitements locaux sont cependant difficiles à mettre en oeuvre et pas toujours très efficaces. Les injections de cortisone dans l’ongle peuvent être proposées en cas d’atteinte de quelques ongles des mains. Les injections à la base de l’ongle sont réalisées pour le psoriasis de la matrice (anomalies de la surface de l’ongle) alors que les injections sous l’ongle sont réalisées pour le psoriasis du lit de l’ongle (ongle décollé). Les injections doivent être réalisées tous les mois pendant 4 à 12 mois, elles nécessitent parfois une anesthésie locale (injections sous l’ongle).
Les traitements internes du psoriasis des ongles sont identiques à ceux du psoriasis de la peau, ils sont utilisés quand l’atteinte des ongles est importante ou altère significativement la qualité de vie des patients. Le médecin peut évaluer l’importance de l’atteinte des ongles à l’aide du NAPSI (Nail Psoriasis Index) et le retentissement sur la qualité de vie par le DLQI (Dermatosis Life Quality Index). Les traitements par voie générale font appel aux dérivés de la vitamine A (Soriatane ®), au méthotrexate (Novatrex®, Ledertrexate®, Methoject®) ou à la ciclosporine A (Néoral®). Le psoriasis unguéal modéré à sévère et résistant aux traitements précédents peut bénéficier des nouveaux traitements biologiques comme l’infliximab (Rémicade®), l’etanercept (Enbrel®), l’adalimumab (Humira®), l’efalizumab (Raptiva®) ou bientôt l’ustekinumab (Stelara®). Ces traitements biologiques ont une efficacité variable mais souvent remarquable, leur utilisation est souvent pratique (une injection par semaine). Les traitements biologiques dépriment en général le système de défense de l’organisme et peuvent favoriser des infections graves ou des cancers. Les traitements biologiques sont pris en charge par l’assurance maladie sous certaines conditions, leur coût est particulièrement élevé avec des prix de l’ordre de 1000 à 2000 € le mois de traitement.
Les traitements du psoriasis capillaire sont maintenant très efficaces, ils permettent d’éliminer les symptômes pendant un temps mais n’évitent pas la récidive de la maladie, c’est la raison pour laquelle un traitement d’entretien est toujours indispensable.
Comment éviter les récidives ?
Les traitements du psoriasis capillaire sont très performants, ils permettent d’effacer les symptômes de la maladie un temps mais n’évitent pas la récidive, c’est la raison pour laquelle le traitement d’entretien doit impérativement suivre le traitement d’attaque, celui ci doit parfois être initié à nouveau à l’oaccsion des poussées. Afin de minimiser les effets secondaires de chaque traitement et maintenir son efficacité, le dermatologue doit envisager des stratégies thérapeutiques tournantes ou l’on passe d’un traitement à un autre.
Maladies associées au psoriasis
Il existe un faisceau de preuves pour étayer une augmentation du risque cardio-vasculaire chez les patients qui présentent un psoriasis en plaque. Une augmentation du risque d’obésité et de syndrome métabolique a été retrouvé chez les patients qui présentent un psoriasis en plaque. Cependant, la relation entre le psoriasis en plaque et risque cardiovasculaire est complexe – la réalité d’une association entre psoriasis en plaque et augmentation du risque cardiovasculaire reste à démontrer.
Quelles sont les perspectives d’avenir
Références bibliographiques
A. C. Foulkes, D. J. C. Grindlay, C. E. M. Griffiths and R. B. Warren. What’s new in psoriasis? An analysis of guidelines and systematic reviews published in 2009–2010. Clinical and Experimental Dermatology.Volume 36, Issue 6, pages 585–589, August 2011.
Acitrétine. L. Dubertret. Annales de Dermatologie et de Vénéréologie. 2011, Vol 138, n° 12 pp 826-8.
Acitrétine. Berbis. Annales de Dermatologie et de Vénéréologie. 2001, vol. 128, no6-7, pp 737-45.
Photothérapies du psoriasis. J.-C. Béani a M. Jeanmougin. Annales de Dermatologie et de Vénéréologie. Volume 138, numéro 12 pages 826-828 (décembre 2011).
A review of targeted ultraviolet B phototherapy for psoriasis. Mudigonda T, Dabade TS, Feldman SR. Center for Dermatology Research, Department of Dermatology, Wake Forest University School of Medicine, Winston-Salem, North Carolina. J Am Acad Dermatol. 2011 Oct.
Photographies
 |
 |
| Psoriasis en plaque dit « vulgaire » | Psoriasis du coude |
 |
 |
| Psoriasis des plis | Psoriasis de l’ongle et de l’articulation |
 |
 |
| Psoriasis pustuleux | Psoriasis pustuleux localisé |
 |
 |
| Psoriasis des paumes et des plantes | Psoriasis des ongles |
 |
 |
| Psoriasis du visage | Psoriasis du cuir chevelu |
Sites internets
http://francepsoriasis.org/
L’association France Psoriasis œuvre pour redonner espoir aux malades, les soutenir et leur apporter des réponses précises. Son travail consiste aussi à sensibiliser les professionnels de santé, les autorités politiques et le grand public sur le Psoriasis.
53 rue Compans, 75019 Paris – Tél : 01 42 39 02 55 – E-mail : info@francepsoriasis.org
L’association Psoriasis-Contact s’attache à fournir des conseils utiles et des informations scientifiquement contrôlées pour améliorer la qualité de vie des patients psoriasiques et les aider à mieux vivre la maladie au quotidien.
Dieweg, 45 – 1180 Bruxelles – Tél : 02 372 37 67 – E-mail : info@psoriasis-contact.be
• DMOZ directory
• Association pour la lutte contre le psoriasis (APLCP)![]()
Informe les patients sur la maladie, les traitements et le calendrier de l’association.
• Groupe d’aide à la recherche et à l’information sur le psoriasis (GIPSO)
Description de la maladie et des traitements, conseils pratiques, l’association avec ses prochaines réunions et le comité scientifique.
• Psoriasis Support
Informations sur le psoriasis, la recherche et son traitement, par le laboratoire Biogen.
• Monpso.netInformations aux patients sur le psoriasis, sous l’égide du laboratoire Léo.
• PsoriasisNet
A patient ressource from the American academy of dermatology.
• National Psoriasis Foundation![]()
Providing information on symptoms, treatments, research, educational programs, photo archives, case histories, and children’s resources. Also offers interactive forums and monthly bulletins.
• Medline Plus : PsoriasisOffers links to news, articles, and research data regarding this disease. Also offers clinical research data, diagnostics and conditions, and newsletters.
• American Academy of Dermatology
Provides information regarding myths, facts, and treatments for this disease. Also offers referrals for dermatologists.
• Psoriatic Arthropathy Alliance
Non-profit organization dedicated to raising awareness of psoriatic diseases. Includes conference schedules, publications and resources, and newsletters.
• National Institute of Arthritis and Musculoskeletal and Skin Diseases : Psoriasis
Concise fact sheet with glossary, causes, diagnosis, treatments, and current research.
• Treatments for Psoriasis
General psoriasis information including types, causes, treatments, and resources.
Also offers information on related skin disorders.
Dermis
• Psoriasis habituel dit « vulgaire »
• Psoriasis en goutte dit « guttata »
• Psoriasis des plis
• Psoriasis pustuleux généralisé
• Psoriasis pustuleux localisé aux paumes et aux plantes
• Psoriasis des ongles